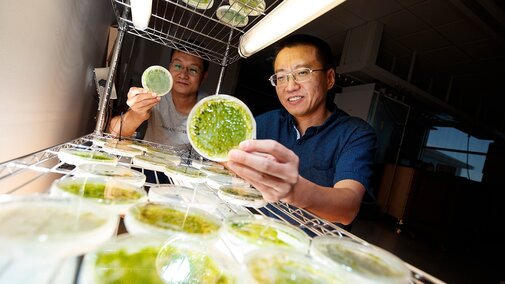
190722_Yin_009-xl

About UNL
The University of Nebraska–Lincoln was chartered as a land-grant university on February 15, 1869, to create opportunity for the state of Nebraska. A proud member of the Big Ten Conference, the Big Ten Academic Alliance, and the Association of Public and Land-grant Universities (APLU), Nebraska is classified within the Carnegie “R1: Doctoral Universities – Highest Research Activity” category. The university is accredited by the Higher Learning Commission.

A Strong Foundation
Always a place of high ambition, this was one of the first institutions west of the Mississippi River to award doctoral degrees—the first being granted in 1896. The University of Nebraska established the world’s first undergraduate psychology laboratory. The discipline of ecology was born here, and the campuses reflect that tradition, being recognized as botanical gardens and arboreta. An early institutional interest in literature and the arts provided the foundations for today’s Prairie Schooner literary magazine, the University of Nebraska Press, and the Sheldon Museum of Art, which houses one of the world’s most significant collections of 20th century American art.
Today, Nebraska is one of the nation’s leading teaching institutions, and a research leader with a wide array of grant-funded projects aimed at broadening knowledge in the sciences and humanities.

Better to Best
The University of Nebraska–Lincoln consistently ranks in the top tier of national research universities. In fact, we are ranked near the top third of all national universities, both public and private. In recent years, Nebraska has been ranked highly for value, graduation rate and access.
Best Value Colleges, The Princeton Review 2023
A Best Law School for Your Money, Money Magazine 2026
Low Costs, High Graduation Rate, U.S. Department of Education College Scorecard

Excellence in Undergraduate Education
The University of Nebraska–Lincoln is a research-extensive institution with an extraordinary focus on undergraduate education. Our undergraduates learn from faculty who create new knowledge, develop one-to-one connections with students and foster a sense of community in their classes. Several signature programs exemplify this commitment to undergraduate success.
The Undergraduate Creative Activities and Research Experiences Program (UCARE) connects faculty and students to work collaboratively on independent study projects that advance new knowledge.
The Jeffrey S. Raikes School of Computer Science and Management develops leaders for this era of expanding information technology and business globalization.
The Johnny Carson Center for Emerging Media Arts guides creative, young pioneers who use technology to innovate, to solve human-scale problems, to entertain audiences, and to tell breathtaking stories that stimulate, provoke and inspire.
Since 1988, the E.N. Thompson Forum on World Issues has hosted a diversity of viewpoints on international and public policy issues on behalf of all Nebraskans to promote understanding and encourage debate.
The Heuermann Lectures focus on the sustainability of food, natural resources, renewable energy and rural communities for all people.

Research & Economic Development
The University of Nebraska–Lincoln is the intellectual center for the state of Nebraska, providing leadership in education and research. The citizens of Nebraska benefit from the knowledge and research generated by our faculty and students, a feature that distinguishes the land-grant mission of our university. The university's research enterprise has achieved record-breaking growth and progress over the past decade, expanding its power to transform lives across Nebraska and around the world.
Legend & Legacy
The University of Nebraska–Lincoln has been home to many legendary figures, including the literary naturalist Loren Eiseley, geneticist George Beadle, scientist Jay Forrester, artists Aaron Douglas and Weldon Kees, social researcher Alvin Johnson, investor Warren Buffett, tech entrepreneur Evan Williams, legal scholar Roscoe Pound, comedian Johnny Carson, diva Barbara Hendricks, artist and engineer Harold Edgerton, General of the Armies John J. Pershing, authors Willa Cather and Mari Sandoz, and many others. Today, students are building on this legacy through their research involvement in fields as diverse as sociology, geosciences, virology and agricultural sciences.
